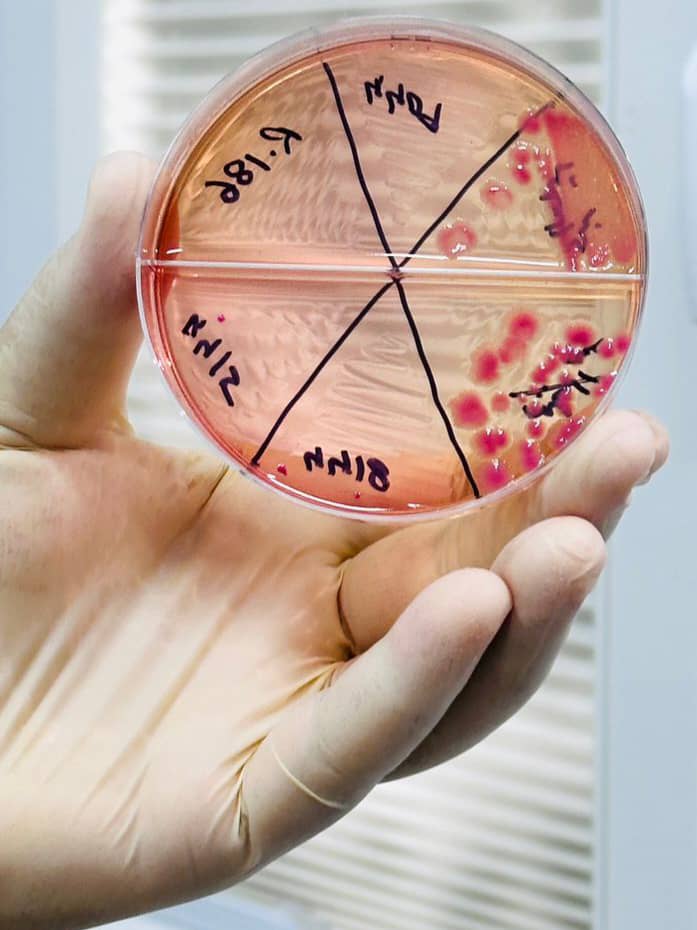
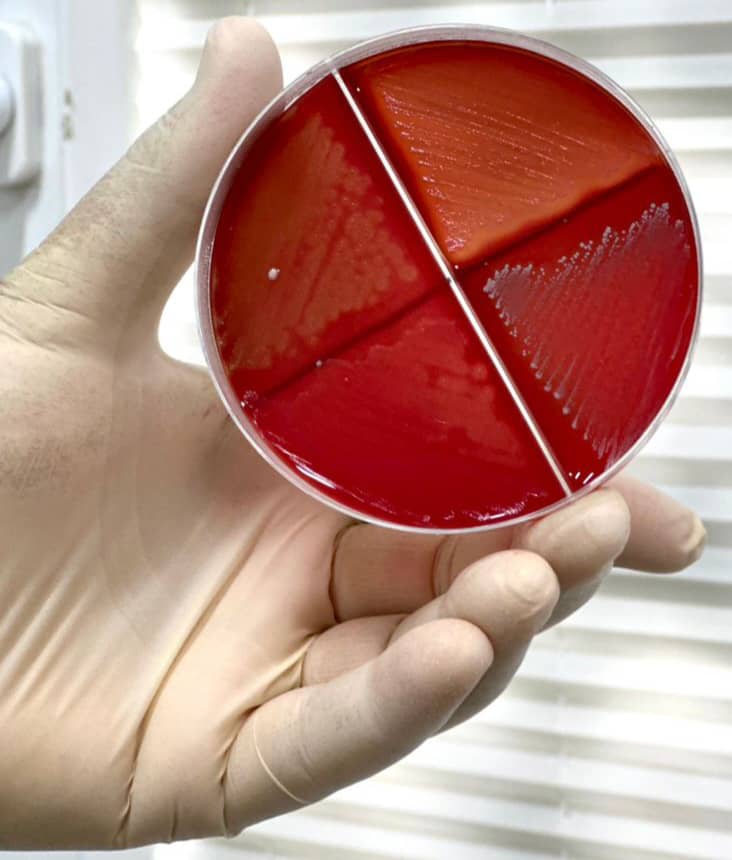

التدريب العملي ضمن مقرر علم الاحياء الدقيقة
2023-11-12 |
جانب العملي لمقرر علم الأحياء الدقيفة 1 حيث يتم تدريب الطلبة على طريقة زراعة و تنمية البكتيريا على الاوساط الزراعية و كيف يتم التعرف و الكشف على السلالات الهامة طبيا
جميع الحقوق محفوظة © جامعة طرابلس الأهلية 2023
برمجة وتصميم شركة طوارئ الحلول